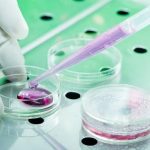

Screening antitubercolare per i bambini della primaria Buricchi
Tutti i bambini della classe IV della Primaria Bogardo Buricchi di Carmignano saranno sottoposti, domani venerdì 24 febbraio, al test di intradermoreazione di Mantoux per screening antitubercolare, in quanto una loro compagna è stata ricoverata martedì per aver contratto l’infezione. Nonostante il caso presenti un livello di contagiosità potenziale molto limitato, il protocollo regionale di […]
Leggi tutto